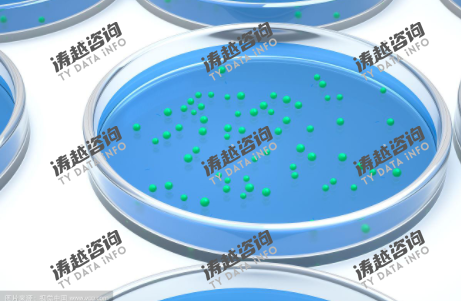

热点追踪:全球三维细胞培养到2031年市场规模将接近78.7亿元
涛越咨询(TY Data) 调研数据显示,2024年全球三维细胞培养市场规模已达36.8亿元,作为生物医药研发的核心技术平台,其通过模拟体内微环境实现细胞立体生长与功能表达,广泛应用于药物筛选、肿瘤研究、再生医学等领域,市场发展深度绑定创新药研发投入、精准医疗推进及细胞治疗产业化进程。在全球创新药研发热潮、肿瘤治疗需求升级及生物技术突破的多重驱动下,2024-2031年市场将以11.6%的高年复合增长率快速扩张,到2031年市场规模将接近78.7亿元。细分市场呈现结构化差异:3D生物打印与微流控芯片等高端技术产品因适配精准研发需求,增速达18.2%,显著高于传统支架培养产品的7.5%,成为拉动市场增长的核心动力。
一、产品定义与核心特征
三维细胞培养是一种模拟体内细胞生长微环境(包括细胞外基质、细胞间相互作用及理化信号),使细胞在三维空间内实现立体增殖、分化并维持特定生理功能的细胞培养技术体系,核心产品涵盖支架类培养产品(天然/合成聚合物支架)、无支架类培养产品(悬滴培养板、旋转生物反应器)及高端技术平台(3D生物打印系统、微流控芯片)三大类。其核心作用是解决传统二维细胞培养与体内生理环境差异大的问题,显著提升药物筛选准确性与疾病模型可靠性,广泛应用于创新药体外评价、肿瘤发生机制研究、干细胞定向分化及组织工程构建等场景。
该技术核心优势突出:一是生理相关性高,培养的细胞形态、基因表达及功能更贴近体内状态,使药物毒性测试准确率从二维培养的40%提升至70%以上;二是应用场景多元,可适配从单种细胞培养到复杂类器官构建的全流程需求;三是技术兼容性强,可与基因编辑、高内涵成像等技术融合,提升研究深度;四是产业化潜力大,为细胞治疗、组织工程等领域提供核心技术支撑。按技术成熟度划分,传统支架类产品(2024年占比58%)单价500-5000元/套,主打基础科研与常规药物筛选需求;高端技术平台(占比42%)集成智能控制与精准构建功能,单价10-500万元/套,适配类器官培养与精准医疗研发场景。2024年全球三维细胞培养产品出货量超500万套,其中制药企业采购占比达45%,成为核心需求来源。从技术趋势看,融合AI算法的高通量三维细胞培养系统因契合创新药研发效率提升需求,2024年市场占比同比提升5.3个百分点,逐步成为高端研发机构标配。
二、市场驱动因素深度解析
(一)创新药研发投入激增,药物筛选需求升级
全球创新药研发进入爆发期,三维细胞培养因提升药物筛选效率与准确性,成为制药企业核心研发工具。2024年全球医药研发投入达2200亿美元,同比增长15%,其中肿瘤药、神经退行性疾病药物研发投入占比超60%,此类复杂疾病药物研发对体外模型生理相关性要求极高,三维细胞培养可有效降低临床前到临床阶段的药物淘汰率(从90%降至75%左右)。辉瑞、罗氏等国际药企在新药研发中三维细胞培养应用率从2020年的35%提升至2024年的78%,单家企业年均采购额超1亿元。中国创新药企业快速崛起,2024年国内1类新药申报达1200项,带动三维细胞培养市场规模同比增长28%,恒瑞医药、百济神州等企业均建立专属三维细胞培养研发平台。
(二)肿瘤研究与精准治疗推进,模型需求增长
全球肿瘤发病率持续上升,精准治疗与个性化医疗发展推动肿瘤模型需求,三维细胞培养成为构建患者来源肿瘤类器官(PDO)的核心技术。世界卫生组织数据显示,2024年全球新发癌症病例超2400万例,肿瘤精准治疗市场规模达1200亿美元,PDO模型可保留患者肿瘤异质性,实现药物敏感性预测与治疗方案个性化制定,准确率达85%以上。美国MD安德森癌症中心通过三维细胞培养构建超1000种PDO模型,用于抗肿瘤药物筛选,2024年相关设备采购量同比增长42%;中国国家癌症中心启动“肿瘤类器官库建设项目”,带动国内肿瘤领域三维细胞培养市场规模达8.2亿元,占全球22%。同时,CAR-T细胞治疗等细胞疗法研发中,三维细胞培养用于模拟肿瘤微环境评估治疗效果,进一步拉动高端设备需求。
(三)生物技术突破,技术迭代升级加速
3D生物打印、微流控芯片等技术与细胞培养深度融合,推动三维细胞培养向精准化、高通量方向升级。3D生物打印技术可实现细胞按体内结构精准排列,构建复杂组织模型,Organovo公司的3D生物打印肝脏组织模型已用于药物肝毒性测试,2024年相关产品销售额同比增长65%;微流控芯片(器官芯片)通过模拟器官生理功能,实现多器官联动培养,Emulate公司的人肺芯片获FDA认可用于药物研发,单价达50万元/套,2024年销量突破1000套。同时,AI技术与三维细胞培养结合,通过算法优化培养参数与分析细胞形态数据,使培养成功率提升30%,谷歌DeepMind与剑桥大学合作开发的AI辅助三维细胞培养系统已在多家科研机构应用,推动高端技术平台需求爆发。
(四)政策支持与资金投入,产业发展加速
全球各国出台政策支持生物医药技术发展,为三维细胞培养提供资金与应用保障。美国《国家生物技术计划》将三维细胞培养列为重点支持技术,2024年联邦资金投入超5亿美元用于相关研发;欧盟“地平线欧洲”计划资助30个三维细胞培养相关项目,总资金达8亿欧元;中国《“十四五”生物经济发展规划》明确支持类器官与器官芯片技术研发,对相关企业给予税收减免与研发补贴,2024年国内三维细胞培养企业获融资超20亿元,较2021年增长3倍。同时,监管政策逐步完善,FDA、NMPA等机构出台三维细胞培养模型用于药物研发的指导原则,推动技术产业化应用,2024年全球有15个基于三维细胞培养数据的新药获批进入临床阶段。
(五)科研机构与CRO行业需求,市场基础夯实
全球科研机构与医药研发外包(CRO)行业规模扩张,为三维细胞培养提供稳定基础需求。2024年全球CRO市场规模达850亿美元,同比增长18%,药明康德、康龙化成等头部CRO企业大规模采购三维细胞培养设备,用于承接国际药企研发订单,药明康德2024年三维细胞培养相关投入超3亿元,建立高通量筛选平台。全球顶尖科研机构经费投入增长,哈佛大学、麻省理工学院等年均采购三维细胞培养产品超2000万元,用于基础生物学研究与技术创新。中国科研机构需求旺盛,2024年国内高校与科研院所采购占比达35%,其中清华大学、上海交通大学在类器官研究领域的采购量同比增长50%,推动基础科研市场稳步增长。
三、市场细分与区域发展格局
(一)产品类型与应用领域分布
按产品类型划分,2024年传统支架类三维细胞培养产品市场规模21.3亿元,占比58.0%,核心优势为成本可控、操作便捷,单价500-5000元/套,基础科研与常规药物筛选需求支撑其发展,预计2031年规模达33.5亿元,CAGR 7.5%;高端技术平台(3D生物打印、微流控芯片等)2024年规模15.5亿元,占比42.0%,具备精准构建、高通量优势,单价10-500万元/套,受益于创新药研发与精准医疗推进,预计2031年规模达45.2亿元,CAGR 18.2%,为增速最快细分品类。
按应用领域划分,2024年药物研发领域市场规模16.5亿元,占比44.8%,创新药研发投入带动需求,预计2031年规模达38.2亿元,CAGR 12.8%;肿瘤研究领域2024年规模9.2亿元,占比25.0%,精准治疗需求推动增长,预计2031年达21.5亿元,CAGR 13.0%;基础科研领域2024年规模6.6亿元,占比17.9%,科研经费增长支撑需求,预计2031年达12.1亿元,CAGR 8.9%;细胞治疗领域2024年规模4.5亿元,占比12.2%,产业化进程加速,预计2031年达12.1亿元,CAGR 15.6%;其他领域(再生医学等)2024年规模0.04亿元,占比0.1%,预计2031年达0.08亿元,CAGR 10.2%。
(二)区域市场增长态势
北美地区2024年市场规模16.5亿元,占比44.8%,为全球最大市场。美国是核心增长极,2024年市场规模14.7亿元,占全球40%,创新药研发与肿瘤研究双轮驱动,增速达15%;加拿大侧重基础科研应用,规模1.8亿元。预计2031年北美规模达35.4亿元,CAGR 11.5%,持续领跑全球。
欧洲地区2024年规模10.3亿元,占比28.0%,德国、英国为核心市场。德国生物医药产业发达,默克、拜耳等企业采购需求带动市场规模4.6亿元;英国聚焦3D生物打印技术研发,规模2.8亿元。预计2031年欧洲规模达22.1亿元,CAGR 11.3%。
亚太地区2024年规模8.8亿元,占比23.9%,中国、日本为核心市场。中国2024年市场规模5.5亿元,占全球15%,创新药企业崛起与政策支持推动增速达28%;日本侧重高端技术引进,规模2.1亿元。预计2031年亚太规模达20.2亿元,CAGR 12.6%,成为增长最快区域。
其他地区(拉美、中东等)2024年规模1.2亿元,占比3.3%,巴西、沙特生物医药产业起步,需求增速达10%-12%,但高端产品依赖进口。预计2031年规模达1.0亿元,CAGR 2.5%。
四、竞争格局与重点企业分析
(一)全球市场竞争格局
全球三维细胞培养市场呈现“国际巨头主导高端、本土企业聚焦中低端”的竞争格局,CR5达62%,行业壁垒集中在核心技术(生物材料研发、精准打印算法)、生物安全性认证及下游客户资源。第一梯队(国际高端龙头)以美国Thermo Fisher、Corning、Organovo为代表,合计占比40%,掌握3D生物打印、器官芯片核心技术,配套辉瑞、罗氏等国际药企,产品毛利率超65%,Thermo Fisher在传统支架类产品领域市占率超30%。第二梯队(区域龙头)包括中国华龛生物、日本JSR、德国默克,合计占比22%,华龛生物国内类器官培养产品市占率达25%,配套恒瑞医药、百济神州;默克聚焦高端生物材料供应,优势突出。第三梯队(中小厂商)合计占比38%,聚焦基础科研用常规产品,依赖性价比竞争,毛利率普遍在20%-30%。
(二)重点企业发展动态
Thermo Fisher(美国):2024年市场份额18%,规模6.6亿元,三维细胞培养全产品线布局,传统支架类产品全球市占率第一,同时推出AI辅助高通量筛选系统,使药物筛选效率提升50%,配套辉瑞、强生等企业,研发投入占比15%,2024年订单量同比增长32%。
Organovo(美国):2024年市场份额10%,规模3.7亿元,3D生物打印技术全球领先,其生物打印肝脏组织模型获FDA认可用于药物肝毒性测试,配套默克、阿斯利康等药企,2024年推出第二代生物打印机,打印精度提升至50μm,销量同比增长65%。
华龛生物(中国):2024年市场份额8%,规模2.9亿元,国产三维细胞培养领军企业,类器官培养支架产品国内市占率25%,核心生物材料国产化率超90%,配套恒瑞医药、中国科学院等机构,2024年海外收入增长85%,进入欧洲科研市场。
Corning(美国):2024年市场份额12%,规模4.4亿元,聚焦无支架类三维细胞培养产品,其超低吸附培养板全球市占率超40%,配套全球顶尖科研机构与CRO企业,2024年与药明康德达成长期合作,年供货量超100万套,销量同比增长28%。
五、技术发展趋势与未来展望
(一)技术创新核心方向
高通量与自动化融合,开发集成培养、成像、分析的一体化系统,Thermo Fisher新一代高通量三维细胞培养平台可同时处理1536个样本,检测效率提升10倍,预计2027年高通量产品占比将超45%。生物材料功能化升级,研发具有细胞定向诱导功能的智能支架,华龛生物推出的干细胞诱导支架可使分化效率提升60%,预计2028年功能化支架渗透率达70%。多器官联动培养,通过微流控技术构建“人体芯片”,Emulate公司的多器官芯片可模拟肝脏-肾脏-肠道联动代谢,用于复杂药物毒性评估,预计2027年多器官芯片市场规模达15亿元。AI与大数据应用,通过算法优化培养条件与预测药物效果,谷歌DeepMind的AI模型可精准预测三维培养细胞的药物响应,准确率达92%,预计2028年AI辅助系统渗透率达55%。
(二)行业挑战与战略建议
行业面临三重挑战:一是核心生物材料依赖,高端水凝胶、生物墨水进口依赖度仍超80%,受生物医药供应链影响较大;二是技术标准不统一,不同企业产品培养结果可比性差,影响产业化应用;三是成本较高,高端3D生物打印机单价超500万元,限制中小研发机构采购。对此建议:技术层面,联合国内材料企业攻关智能生物材料与生物墨水,2027年实现中高端材料国产化率超60%,突破多器官芯片核心技术;市场层面,头部企业聚焦创新药研发高端市场,中小企业深耕基础科研与常规产品领域,形成差异化竞争;标准层面,推动行业协会制定三维细胞培养技术标准,华龛生物已参与制定中国类器官培养标准;政策层面,依托“重大新药创制”科技专项,申请研发补贴与成果转化支持,加快国产高端产品推广。
关于涛越咨询(TY Data)
涛越咨询(TY Data)始终专注于定制研究、管理咨询、IPO咨询、产业链研究、数据库建设及顶级行业服务。依托大型基础数据库,结合生物医药、细胞工程、创新药研发等领域10年以上经验的专家资源,为客户提供专业精准的市场洞察与咨询服务。
媒体联络
如需获取报告全文或进行采访,可通过以下方式联系:电话:17266215695;邮箱:market@tydatainfo.com、sale@tydatainfo.com、hr@tydatainfo.com